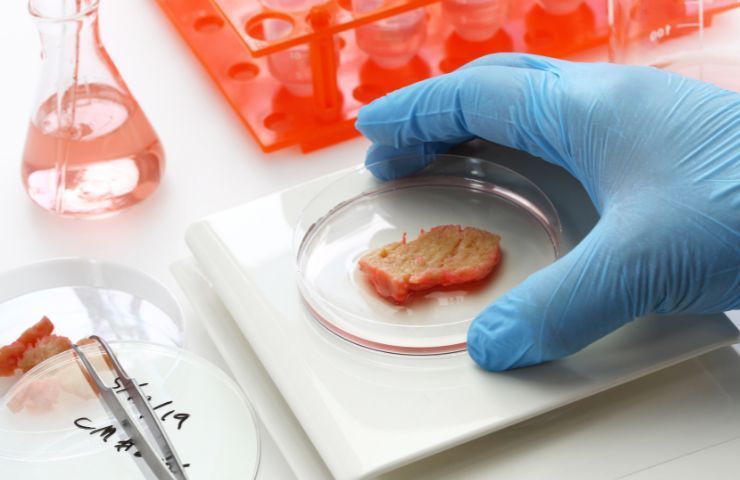

Tempo fa avevamo parlato del via libera alla carne coltivata negli USA, ma vietata in Europa, quali sono le ultime notizie?

Inutile girarci intorno, la carne coltivata in laboratorio, generata da cellule animali, è il cibo del futuro. È impossibile pensare di soddisfare le esigenze di miliardi di persone sul pianeta, facendo affidamento agli allevamenti tradizionali. E non è un caso se, per alimentare questa macchina del macello, continuino a nascere allevamenti intensivi, luoghi atroci e infernali che andrebbero aboliti.
L’unica soluzione è produrre carne coltivata, creata senza l’uccisione di animali, senza maltrattamenti, senza inquinare. Dunque, si tratta di un alimento sostenibile, che non ha impatto sull’ambiente, e che non calpesta la dignità e la vita di esseri innocenti. Tra l’altro, si tratta di carne vera, dato che è generata da cellule animali, prelevate direttamente dagli alimenti, perciò del tutto identica alla fonte primaria.
Le ultime notizie per quanto riguarda la carne coltivata, ancora tutto fermo
Preservare il benessere animale dovrebbe essere l’obiettivo comune, ma forse in pochi hanno la sensibilità di capire un concetto tanto semplice. Non si tratterebbe neanche di cambiare le proprie tradizioni, ma di fare una scelta consapevole. Certo, cambierebbe il commercio alimentare, si trasformerebbero gli allevamenti, e la Coldiretti, in maniera ipocrita, condanna la carne in laboratorio, per difendere gli allevatori.
Condanna la carne coltivata, non sa neanche per quale motivo, definendola “non affidabile”, per difendere l’intera filiera italiana. È comprensibile, ma ingiustificato, dato che la carne coltivata, come accennato, è carne vera, derivante da cellule animali, ed è molto più sicura rispetto alla carne derivante da allevamenti intensivi, dove gli animali vivono l’inferno e sono imbottiti con chissà quali sostanze.
Il 20 luglio scorso, in Senato è stata vietata definitivamente la produzione e il commercio della carne coltivata in laboratorio. Per la produzione della carne si prelevano le cellule muscolari dell’animale, quindi senza fargli del male, senza ucciderlo, e poi le cellule staminali sono portate in un bioreattore. Il bioreattore è un dispositivo in grado di riprodurre temperatura ideale per far proliferare le cellule.
La soluzione a miliardi di uccisioni è a portata di mano

Per questo motivo, questa tecnica si definisce di coltivazione, proprio per la proliferazione di cellule in ambiente artificiale. In pratica, si fanno crescere in laboratorio, al posto di crescere in un normale organismo, ma gli effetti sono del tutto simili. Si tratta di carne vera, e non sintetica, dove le molecole sono assemblate partendo da zero.
L’avversione del nostro Governo verso questo tipo di carne è davvero ridicola. Le motivazioni per contrastarla, come accennato, sono diverse, a cominciare dalla protezione degli allevatori. Ma il processo di trasformazione e l’innesto di una nuova tradizione commerciale avverrebbe in tempi lunghi, prima che il popolo compri carne coltivata passerebbero anni, forse decenni, e ci sarebbe tutto il tempo per adeguarsi.
Ma in questo modo si combatterebbero seriamente gli allevamenti intensivi. Non ci vuole molto per capire. Se la UE vuole seriamente lottare per la salute ambientale e per il benessere degli animali, dovrebbe dare il via libera a questo tipo di carne, così come hanno fatto gli Stati Uniti già dall’inizio dell’anno. Non siamo più nel Medioevo, la soluzione a tanta sofferenza e a miliardi di uccisioni l’abbiamo a portata di mano.






